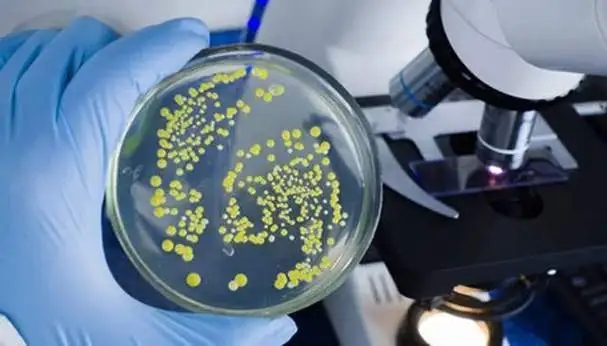

GLP认证咨询-药物重复给药毒性试验技术指导原则
药物重复给药毒性试验技术指导原则
一、概述
重复给药毒性试验是描述动物重复接受受试物后的毒性特征,它是非临床安全性评价的重要内容。重复给药毒性试验可以:①预测受试物可能引起的临床不良反应,包括不良反应的性质、程度、量效和时效关系、以及可逆性等;②判断受试物重复给药的毒性靶器官或靶组织;③如果可能,确定未观察到临床不良反应的剂量水平(No Observed Adverse Effect Level,NOAEL);④推测第一次临床试验(First in Human, FIH)的起始剂量,为后续临床试验提供安全剂量范围;⑤为临床不良反应监测及防治提供参考。
本指导原则适用于中药、天然药物和化学药物。
二、基本原则
药物安全性评价试验必须执行《药物非临床研究质量管理规范》(GLP),药物重复给药毒性试验是药物研发体系的有机组成部分,试验设计要重视与其他药理毒理试验设计和研究结果的关联性,要关注同类药物临床使用情况、临床适应症和用药人群、临床用药方案,还要结合受试物理化性质和作用特点,使得重复给药毒性试验结果与其他药理毒理试验研究互为说明、补充或/和印证。
三、基本内容
(一)受试物
中药、天然药物:受试物应采用能充分代表临床试验拟用样品和/或上市样品质量和安全性的样品。应采用工艺路线及关键工艺参数确定后的工艺制备,一般应为中试或中试以上规模的样品,否则应有充分的理由。应注明受试物的名称、来源、批号、含量(或规格)、保存条件、有效期及配制方法等,并提供质量检验报告。由于中药的特殊性,建议现用现配,否则应提供数据支持配制后受试物的质量稳定性及均匀性。当给药时间较长时,应考察配制后体积是否存在随放置时间延长而膨胀造成终浓度不准的因素。如果由于给药容量或给药方法限制,可采用原料药进行试验。试验中所用溶媒和/或辅料应标明名称、标准、批号、有效期、规格及生产单位。
化学药物:受试物应采用工艺相对稳定、纯度和杂质含量能反映临床试验拟用样品和/或上市样品质量和安全性的样品。受试物应注明名称、来源、批号、含量(或规格)、保存条件、有效期及配制方法等,并提供质量检验报告。试验中所用溶媒和/或辅料应标明名称、标准、批号、有效期、规格和生产单位等,并符合试验要求。
在药物研发的过程中,若受试物的工艺发生可能影响其安全性的变化,应进行相应的安全性试验。
化学药物试验过程中应进行受试物样品分析,并提供样品分析报告。成分基本清楚的中药、天然药物也应进行受试物样品分析。
(二)实验动物
重复给药毒性试验通常采用两种实验动物,一种为啮齿类,另一种为非啮齿类。理想的动物应具有以下特点:①对受试物的代谢与人体相近;②对受试物敏感;③已有大量历史对照数据,来源、品系、遗传背景清楚。在重复给药毒性试验前应采用合适的试验方法对实验动物种属或品系进行选择。通常,啮齿类动物首选大鼠、非啮齿类动物首选Beagle犬,特殊情况下可选用其他种属或品系动物进行重复给药毒性试验,必要时选用疾病模型动物进行试验。
实验动物应符合国家对相应等级动物的质量规定要求,具有实验动物质量合格证明。
一般选择正常、健康、性成熟动物,同性别体重差异应在平均体重的20%之内。
应根据试验期限和临床拟用人群确定动物年龄,一般大鼠为6~9周龄,Beagle犬6~12月龄,猴3~5岁,动物年龄应尽量接近,应注明开始给药时动物年龄。
每个剂量组动物数,啮齿类一般不少于15只/性别(主试验组10只,恢复组5只),非啮齿类一般不少于5只/性别(主试验组3只,恢复组2只)。
(三)给药方案
- 1. 给药剂量:重复给药毒性试验原则上至少应设低、中、高3个剂量组,以及1个溶媒(或辅料)对照组,必要时设立空白对照组和/或阳性对照组;高剂量原则上使动物产生明显的毒性反应,低剂量原则上相当或高于动物药效剂量或临床使用剂量的等效剂量,中剂量应结合毒性作用机制和特点在高剂量和低剂量之间设立,以考察毒性的剂量-反应关系。
- 2. 给药途径:原则上应与临床拟用途径一致,如不一致则应说明理由。
- 3. 给药频率:原则上重复给药毒性试验中动物应每天给药,特殊类型的受试物就其毒性特点和临床给药方案等原因,可根据具体药物的特点设计给药频率。
- 4. 试验期限:建议分阶段进行重复给药毒性试验以支持不同期限的临床试验。试验期限的选定可以根据拟定的临床疗程、适应症、用药人群等进行设计。一般重复给药毒性试验的试验期限与所支持的临床试验及上市申请的关系详见附录(一)。
(四)检测指标
重复给药毒性试验应检测指标详见附录(二)。此外,还应结合受试物的特点及其他试验中已观察到的改变或背景信息(如关于处方组成成分毒性的文献报道等),在不影响正常毒性观察和检测的前提下增加合理的指标。实验动物相关指标的历史背景数据在重复给药毒性试验中具有重要的参考意义。
在结束动物安乐死时进行一次全面检测;当试验期限较长时,应根据受试物的特点及相关信息选择合适的时间点进行阶段性检测;试验期间对濒死或死亡动物应及时采集标本进行检测,分析濒死或死亡的原因;恢复期结束时进行一次全面的检测。
给药前应对动物进行适应性饲养,啮齿类动物应不少于5天,非啮齿类动物不少于2周。在适应性饲养时,对实验动物进行外观体征、行为活动、摄食情况和体重检查,非啮齿类动物至少应进行2次体温、血液学、血液生化学和至少1次心电图检测。
给药期间,根据试验期限的长短和受试物的特点确定检测时间和检测次数。原则上应尽早发现毒性反应,并反映出观测指标或参数变化与试验期限的关系。
给药结束,对主试验组动物进行系统的大体解剖,称重主要脏器并计算脏器系数;进行组织病理学检查并出具完整的病理学检查报告,如发现有异常变化,应附有相应的组织病理学照片。非啮齿类动物对照组和各给药组主要脏器组织均应进行组织病理学检查;啮齿类动物对照组、高剂量组、尸检异常动物应进行详细检查,如高剂量组动物某一组织发生病理改变,需要对其他剂量组动物的相同组织进行组织病理学检查;通常需要制备骨髓涂片,以便当受试物可能对动物造血系统有影响时进行骨髓检查。
给药结束后,继续观察恢复期动物,以了解毒性反应的可逆性和可能出现的迟发毒性;应根据受试物代谢动力学特点、靶器官毒性反应和恢复情况确定恢复期的长短,一般情况下应不少于4周。
(五)伴随毒代动力学
重复给药毒性试验应伴随进行药物毒代动力学试验,具体内容参照相应指导原则。
四、结果分析与评价
重复给药毒性试验的最终目的在于预测人体可能出现的毒性反应。只有通过对试验结果的科学分析和全面评价才能够清楚描述动物的毒性反应,并推断其与人体的相关性。重复给药毒性试验结果的分析和评价是重复给药毒性试验的必要组成部分。
(一)试验结果的分析
分析重复给药毒性试验结果,判断动物是否发生毒性反应及毒性靶器官,描述毒性反应的性质和程度(包括毒性反应的起始时间、程度、变化规律和消除时间),如果有动物死亡应分析死亡原因,确定安全范围,并探讨可能的毒性作用机制。
- 正确理解试验数据的意义
在对重复给药毒性试验结果进行分析时,应正确理解均值数据和个体数据的意义。啮齿类动物重复给药毒性试验中组均值的意义通常大于个体动物数据的意义,实验室历史背景数据和文献数据可以为结果的分析提供参考;非啮齿类动物单个动物的试验数据往往具有重要的毒理学意义,是试验动物数量较少、个体差异较大的原因。此外,非啮齿类动物试验结果必须与给药前数据、对照组数据和实验室历史背景数据进行多重比较,要考虑文献数据参考价值有局限性。在分析重复给药毒性试验结果时应综合考虑数据的统计学意义和生物学意义,正确利用统计学假设检验有助于确定试验结果的生物学意义,要考虑具有统计学意义并不一定代表具有生物学意义;在判断生物学意义时要考虑参数变化的剂量-反应关系、其他关联参数的改变、与历史背景数据的比较等因素;分析试验结果时,须对出现的异常数据应判断是否由受试物毒性引起并给予科学解释。
- 2. 正确判断毒性反应
给药组和对照组之间检测结果的差异可能来源于受试物有关的毒性、动物对药物的适应性改变或正常的生理波动,也可能源于试验操作失误和动物应激。在分析试验结果时,应关注参数变化的剂量-反应关系、组内动物的参数变化幅度和性别差异,同时综合考虑多项毒理学指标的检测结果,分析其中的关联和受试物作用机制,以正确判断药物的毒性反应。单个参数的变化往往并不足以判断化合物是否引起毒性反应,可能需要进一步进行相关的试验。此外,毒代动力学试验可以为毒性反应和毒性靶器官的判断提供重要的参考依据。
(二)动物毒性反应对于临床试验的意义
将重复给药毒性试验结果外推至人体时,不可避免地会涉及到受试物在动物和人体内毒性反应之间的差异。首先,不同物种、同物种不同种属或个体之间对于某一受试物的毒性反应可能存在差异;其次,由于在重复给药毒性试验中通常采用较高的给药剂量,受试物可能在动物体内呈非线性动力学代谢过程,从而导致与人体无关的毒性反应;另外,重复给药毒性试验难以预测一些在人体中发生率较低的毒性反应或仅在小部分人群中出现的特异质反应;同时有些毒性反应目前在动物中难以观察,如头痛、头昏、头晕、皮肤搔痒、视物模糊等。鉴于以上原因,动物重复给药毒性试验的结果不一定完全再现于人体临床试验。但如果没有试验或文献依据证明受试物对动物的毒性反应与人体无关,在进行药物评价时必须首先假设人最为敏感,重复给药毒性试验中动物的毒性反应将会在临床试验中出现。进行深入的作用机制研究将有助于判断动物和人体毒性反应的相关性。
(三)综合评价
重复给药毒性试验是药物非临床安全性研究的有机组成部分,是药物非临床毒理学研究中综合性最强、获得信息最多和对临床指导意义最大的一项毒理学试验。对其结果进行评价时,应结合受试物的药学特点,药效学、药代动力学和其他毒理学的试验结果,以及已取得的临床试验结果,进行综合评价。对于重复给药毒性试验结果的评价最终应落实到受试物的临床不良反应、临床毒性靶器官或靶组织、安全范围、临床需重点检测的指标,以及必要的临床监护或解救措施。
五、参考文献
1.化学药物长期毒性试验技术指导原则. 国家药品监督管理局,2005.3.
2.中药、天然药物长期毒性试验技术指导原则. 国家药品监督管理局,2005.3.
3.周宗灿. 毒理学基础. 第二版. 北京医科大学出版社,2000.
4.秦伯益. 新药评价概论. 第二版 人民卫生出版社,1998.
5.Guidance on nonclinical safety studies for the conduct of human clinical trials and marketing authorization for pharmaceuticals , ICH /M3(R2) 2009.6.
6.Guideline on repeated dose toxicity, EMA 2010.3.
7.Redbook 2000 IV.C, FDA 2003,2007.
8.Note for guidance on toxicokinetics: The assessment of systemic exposure in toxicity studies, ICH /S3A 2007.
六、注释
(一)试验期限的考虑
试验期限应与拟开展的临床试验期限和上市要求相匹配;通过较短试验期限的毒性试验获得的信息,可以为较长试验期限的毒性试验设计提供给药剂量、给药频率、观察指标等方面的参考;同时,临床试验中获得的信息有助于设计较长试验期限的动物毒性试验方案,降低药物开发的风险。以不同试验期限的重复给药毒性试验支持不同用药期限的临床试验及上市评价时,重复给药毒性试验内容都应完整、规范,结果分析评价强调客观性、注重科学性。
拟试验的临床适应症如有若干项,应按最长疗程的临床适应症来确定重复给药毒性试验的试验期限。
(二)剂量设计的考虑
剂量设计应考虑之前进行的各项试验所评价的终点、受试物的理化性质和生物利用度等;局部给药应保证充分的接触时间。高剂量应出现明显毒性反应,或达到最大给药量(Maximum Feasible Dose, MFD),或系统暴露量达到临床系统暴露量的50倍(基于AUC)。如需要在试验中途改变给药剂量,应说明剂量调整理由,完整记录剂量调整过程。
(三)不同情况中药、天然药物的试验要求
考虑到中药、天然药物各类药物处方来源、立题依据等差别,在具体进行试验时可参照以下要求进行。这些要求仅是一般要求,应遵循新药开发的客观规律,具体试验结合受试物特点考虑需开展的试验,进行个性化的设计。
1.未在国内上市销售的从中药、动物、矿物等物质中提取的有效成分及其制剂,新发现的药材及其制剂,新的中药材代用品、药材新的药用部位及其制剂,未在国内上市销售的从中药、动物、矿物等物质中提取的有效部位制成的制剂,未在国内上市销售的中药、天然药物注射剂。以上情况,由于其物质基础较传统中药发生了明显改变,或应用经验较少,为全面考察受试物的重复给药毒性反应情况,应采用啮齿类和非啮齿类两种动物进行重复给药毒性试验。
2.未在国内上市销售的由中药、天然药物组成的非注射给药的复方制剂可先进行一种动物(啮齿类)的重复给药毒性试验,当发现有明显毒性时,为进一步研究毒性情况,再采用第二种动物(非啮齿类)进行试验。若该类处方中含有毒性药材[见注释(四)]、无法定标准药材或有十八反、十九畏等配伍禁忌时,则应进行两种动物(啮齿类和非啮齿类)的重复给药毒性试验。天然药物组成的非注射给药的复方制剂临床试验前采用啮齿类和非啮齿类两种动物进行重复给药毒性试验。
3.改变国内已上市销售药品给药途径(不包括由非注射剂改为注射剂)的制剂、不改变给药途径的非注射给药改剂型制剂和改工艺制剂,建议增设一个原给药途径、原剂型或原工艺的高剂量对照组,先进行一种动物(啮齿类)的重复给药毒性试验。如发现与原给药途径、原剂型或原工艺制剂不同的明显毒性反应或更严重的毒性反应,应进行另一种动物(非啮齿类)的重复给药毒性试验。
4.增加新的适应症或者功能主治的品种如需延长用药期限或增加剂量者,应结合原品种的申报资料及处方组成的情况,确定是否需进行重复给药毒性试验。
(四)中药毒性药材品种
毒性药材:系指收入国务院《医疗用毒性药品管理办法》的中药品种。即:砒石、砒霜、水银、生马钱子、生川乌、生草乌、生白附子、生附子、生半夏、生南星、生巴豆、斑蝥、青娘虫、红娘虫、生甘遂、生狼毒、生藤黄、生千金子、生天仙子、闹羊花、雪上一枝蒿、红升丹、白降丹、蟾酥、洋金花、红粉、轻粉、雄黄。
另外,凡在近年来发现的有毒性作用的药材(原材料)或在复方中含有明显有毒组分的,均按毒性药材处理。
七、附录
(一)试验期限
支持药物临床试验
|
最长临床试验期限 |
重复给药毒性试验的最短期限 |
|
|
啮齿类动物 |
非啮齿类动物 |
|
|
£ 2周 |
2周 |
2周 |
|
2周~6个月 |
同临床试验 |
同临床试验 |
|
> 6个月 |
6个月 |
9个月1、2 |
支持药物上市申请
|
临床拟用期限 |
啮齿类动物 |
非啮齿类动物 |
|
£ 2周 |
1个月 |
1个月 |
|
2周~1个月 |
3个月 |
3个月 |
|
1个月~ 3个月 |
6个月 |
6个月 |
|
>3 个月 |
6个月 |
9个月1、2 |
注:
- 非啮齿类动物不超过6个月期限的试验可接受情况:
当免疫原性或耐受性问题使更长期限的试验难以进行时;
重复、短期用药(即便临床试验期限6个月以上)的疾病,如偏头痛、勃起障碍、单纯性疱疹等的反复间歇给药时;
拟用于危及生命的疾病(如进展性疾病、辅助使用的肿瘤化疗药)时。
2.如果儿童为主要拟用药人群,而已有毒理学或药理学研究结果提示可能发生发育毒性,应考虑在幼年动物上进行长期毒性试验。该试验应采用合适年龄和种系的动物,试验观察指标应针对发育方面的毒性,试验期限犬12个月、大鼠6个月。12个月的犬试验期限应涵盖其发育的全过程。这些幼年动物的长期试验可用于替代标准的长期毒性试验和单独的幼年动物试验。
(二)检测指标
|
项目类别 |
指标 |
|
|
1.临床观察 |
外观、体征、行为活动、腺体分泌、呼吸、粪便性状、给药局部反应、死亡情况等。 |
|
|
2.摄食量、体重、眼科检查 |
|
|
|
3.体温和心电图检测(非啮齿动物) |
|
|
|
4.血液学检测 |
红细胞计数、血红蛋白、红细胞容积、平均红细胞容积、平均红细胞血红蛋白、平均红细胞血红蛋白浓度、网织红细胞计数、白细胞计数及其分类、血小板计数、凝血酶原时间、活化部分凝血活酶时间等。 |
|
|
5.血液生化学检测 |
天门冬氨酸氨基转换酶、丙氨酸氨基转换酶、碱性磷酸酶、肌酸磷酸激酶、尿素氮(尿素)、肌酐、总蛋白、白蛋白、血糖、总胆红素、总胆固醇、甘油三酯、γ-谷氨酰转移酶、钾离子浓度、氯离子浓度、钠离子浓度。 |
|
|
6.尿液观察和分析 |
尿液外观、比重、pH值、尿糖、尿蛋白、尿胆红素、尿胆原、酮体、潜血、白细胞。 |
|
|
7.组织病理学检查的脏器组织 |
⑴需称重并计算脏器系数的器官 |
脑、心脏、肝脏、肾脏、肾上腺、胸腺、脾脏、睾丸、附睾、卵巢、子宫、甲状腺(含甲状旁腺)1。 |
|
⑵需进行组织病理学检查的组织或器官 |
肾上腺、主动脉、骨(股骨)、骨髓(胸骨)、脑(至少3个水平)、盲肠、结肠、子宫和子宫颈、十二指肠、附睾、食管、眼、胆囊(如果有)、哈氏腺(如果有)、心脏、回肠、空肠、肾脏、肝脏、肺脏(附主支气管)、淋巴结(一个与给药途径相关,另一个在较远距离)、乳腺、鼻甲2、卵巢和输卵管、胰腺、垂体、前列腺、直肠、唾液腺、坐骨神经、精囊(如果有)、骨骼肌、皮肤、脊髓(3个部位:颈椎、中段胸椎、腰椎)、脾脏、胃、睾丸、胸腺(或胸腺区域)、甲状腺(含甲状旁腺)、气管、膀胱、阴道、所有大体观察到异常的组织、组织肿块和给药部位。 |
|
注:
- 1. 仅在非啮齿类动物称重。
- 2. 针对吸入给药的给药制剂。
下一篇:已是最后一篇新闻














18576401396